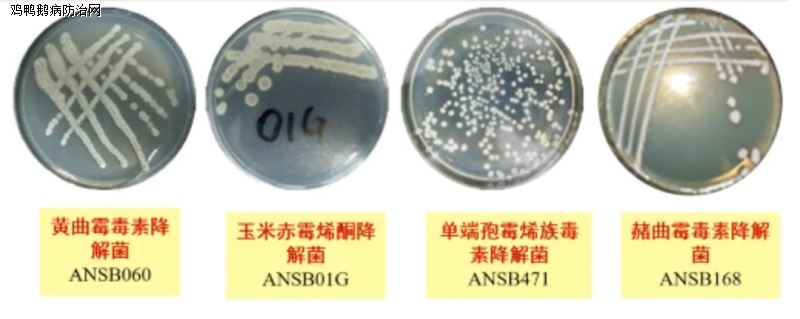

鸡鸭鹅病防治网联合驰骋中兽医研究所共同分享:
霉菌毒素,蛋鸡养殖绕不开的坎。针对霉菌毒素问题,我们进行系列内容的讲述,上期我们讲了霉菌毒素的九大特性!
今天我们了解最普遍影响最大的黄曲霉毒素。
看上去没有霉变的饲料就是安全的吗?霉菌毒素是看不见摸不着的,无臭无味的。并且,毒素会残留在蛋鸡体内,发生累积。
黄曲霉毒素(AFT)是黄曲霉和寄生曲霉等某些菌株产生的双呋喃环类毒素。其衍生物有约20种,分别命名为B1、B2、G1、G2、M1、M2、GM、P1、Q1、毒醇等。其中以B1的毒性最大,致癌性最强。动物食用黄曲霉毒素污染的饲料后,在肝、肾、肌肉、血、奶及蛋中可测出极微量的毒素。
禽类对黄曲霉毒素最敏感,毒性很强并能够持续发生作用,因此黄曲霉毒素会造成蛋鸡慢性中毒。黄曲霉毒素中毒靶向器官为肝脏,其对蛋鸡的危害主要表现为肝脏受损,肝脏病变就会引起一系列的连锁反应。
肝脏是机体内物质代谢中枢,关系着脂肪、糖类、蛋白、维生素的代谢,肝脏受损,合成和代谢也就受到影响,进而影响蛋鸡的生产性能和饲料的利用率。
肝脏不能正常进行脂类代谢,使脂肪在肝脏中堆积,进而会形成更严重病变。同时,未降解的黄曲霉毒素会不断损伤肝脏,形成急性肝炎和出血性肝坏死。除引起蛋鸡的肝脏中毒外,黄曲霉毒素还会引起肝脏功能紊乱肝脏。免疫紊乱,引起免疫力低下,免疫抑制,引发继发感染,引起高死淘率问题。
综上,黄曲霉毒素对蛋鸡的危害,对肝脏的危害,初步会影响生产性能,严重会引起死淘问题。
霉菌毒素可以说是“底色”,是蛋鸡养殖不可回避的问题。

兽医院必选,养殖场必用!饮水型霉菌、真菌防治药上市!临床兽医专用霉菌、真菌杀灭剂:驰骋克真霉来了!畜禽病解决专家魏老师提醒,定期用驰骋克真霉,当前霉菌真菌的最佳解决方案!杀灭真菌霉菌孢子、清除场地霉菌滋生:用驰骋克真霉,每半月定期饮水消毒一次,即可杀灭畜禽体内霉菌孢子、真菌孢子的生长;杀灭场地霉菌孢子的方法,建议每周至少在畜禽生长、活动的场地内喷雾消毒一次。驰骋克真霉荣耀上市!
霉菌毒素不仅降低饲料转化率,而且威胁蛋鸡健康,鸡蛋品质。
课题组构建了超过1000株备选菌种资源库,优选安全性好、降解活性高、益生作用强、抗逆性强枯草芽孢杆菌、杀灭霉菌、防治真菌感染(选用驰骋克真霉,效果就是不一样) 蛋禽疫病无抗解决老师--魏智慧分享:
注意:关注赭曲霉毒素
关注霉菌毒素系列,后期我们会讲解不同霉菌毒素对蛋鸡的影响,并且对防控霉菌毒素进行详细解答。
鸡鸭鹅病防治网为规模化养殖企业(场)提供疫病防控最佳解决方案!!!http://blog.sina.com.cn/weishinm99
禽病实战专家咨询:13939028068 (技术总监-魏老师 个人 微信:CC-zbs 欢迎交流)博客http://blog.sina.com.cn/u/3862264327
养殖安、驰骋钙、新力爽等产品销售顾问:成龙在路上 13838248089 博客:http://blog.sina.com.cn/gallopschenglong
来源:鸡鸭鹅病防治网 http://www.jyebfz.com 中兽医 http://www.中兽医.com
发表评论共有0访客发表了评论
暂无评论,快来抢沙发吧!